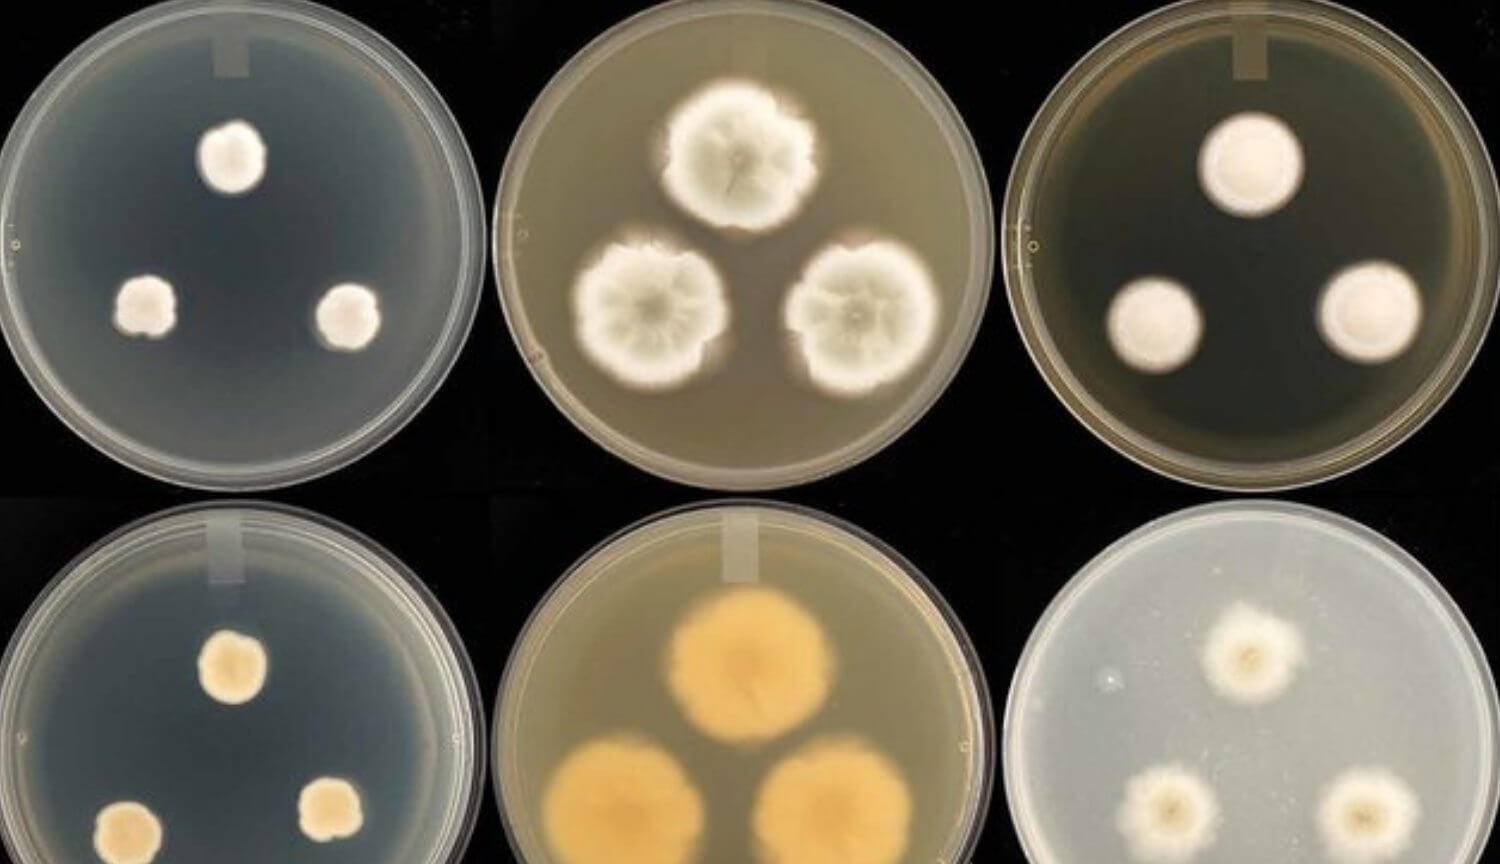
Плесень может противостоять дозам радиации, которые убивают человека.. Чем опасна плесень?. Фото.

С самого начала работы космических станций, на их внутренних поверхностях начали обнаруживаться микроорганизмы, в том числе и плесневые грибы. Например, на станции «Мир» в большом количестве были найдены споры плесени рода пеницилл, которые в земных условиях обычно образуются на пищевых продуктах. Считается, что некоторые из них могут вызывать коррозию алюминиевых сплавов, но чем они опасны в космосе, пока неизвестно. Тем не менее они представляют опасность для оборудования, которое может быть использовано при колонизации Марса — исследователи из Германского центра авиации доказали, что они выживают даже при экстремальном уровне радиации.

Открытие было сделано в ходе эксперимента, где группа ученых под руководством Марты Кортезо поместили споры грибов в условия, близкие к условиям открытого космоса. Их подвергали рентгеновскому и ультрафиолетовому излучению и следили за тем, как протекает их рост. Выяснилось, что плесень способна выжить даже после поглощения 500 грей излучения — это в сотни раз выше, чем смертельная доза облучения для человека. В случае с ультрафиолетовым излучением, споры выдержали мощность в 3 000 Джоулей на квадратный метр.
Чем опасна плесень?
По словам Марты Кортезо, стойкая к радиации плесень может помешать проведению долгосрочных космических миссий. Например, как и говорилось выше, она может способствовать образованию коррозии, и выводить оборудование из строя. Исходя из этого, сотрудникам космических агентств придется как минимум тщательно очищать внутреннюю и наружную части корабля, учитывая высокую живучесть плесени.
Споры пеницилла
Помимо проблем с оборудованием, некоторые виды плесени могут отразиться на здоровье самих космонавтов. Например, на Международной космической станции уже были обнаружены споры грибков Aspergillus fumigatus и Rhodotorula mucilaginosa, которые могут стать причиной инфекционных заболеваний у людей с ослабленной иммунной системой. Помимо бесстрашия перед радиацией, грибки также не боятся химических средств и высоких температур.
На данный момент у ученых нет эффективных средств борьбы с устойчивыми видами плесени, но они, вероятно, уже разрабатывают их.
Рекомендуем к прочтению: На аукционе за 15 тысяч долларов был продан 90-летний образец плесени
Если вам интересны новости науки и технологий, подпишитесь на наш канал в Яндекс.Дзен. Там вы найдете материалы, которые не были опубликованы на сайте!



Новости, статьи и анонсы публикаций
Чат с читателямиСвободное общение и обсуждение материалов